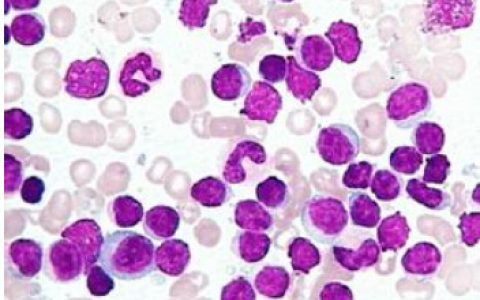
每日一题_2023.05.08

A 45-year-old woman with a long history of menstrual irregularities and infertility presents with complaints of worsening vision. A thorough review of systems reveals the presence of constipation, cold intolerance, and increased pigmentation of skin. The physician performs basic visual field testing and maps the visual disturbance in the patient’s chart. Which of the following visual field defects is most likely in this patient?
一名有长期月经不调和不孕史的45岁女性主诉视力恶化。对各系统的全面检查显示存在便秘、寒冷不耐受和皮肤色素沉着增加。医师进行基本的视野测试,并在病人的病历中标出视觉障碍。该患者最可能出现下列哪一种视野缺损?

(A) A
(B) B
(C) C
(D) D
(E) E
答案解析:
患者有继发于压迫视交叉病变的双颞侧偏盲。月经不调、寒冷不耐受、便秘和皮肤色素沉着增加的病史提示多种内分泌紊乱,可归因于垂体前叶功能障碍。由于垂体与视交叉的解剖关系密切,垂体的扩大病变可压迫视交叉,导致双侧视野颞部视力丧失。这是因为在视交叉中,每只眼的鼻侧(或内侧)视网膜纤维负责颞侧(或外侧)半侧区域,如上图所示。导致双颞侧偏盲的常见病变包括垂体腺瘤、脑膜瘤、颅咽管瘤和下丘脑胶质瘤。
正确答案:B
原创文章(本站视频密码:66668888),作者:xujunzju,如若转载,请注明出处:https://zyicu.cn/?p=16095

 微信扫一扫
微信扫一扫  支付宝扫一扫
支付宝扫一扫